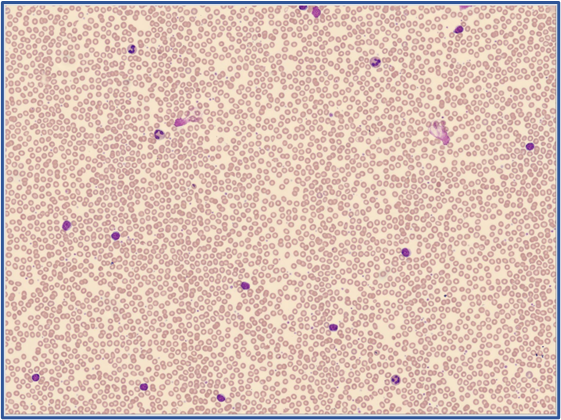
RBC overview Global Test 2025:4

CellaVision Global Test 2025:4 – Chronic Lymphocytic Leukemia (CLL)
Case Description
A 68-year-old man presented to the outpatient clinic for evaluation after his primary physician noted an elevated white blood cell count during a routine examination. The patient reported mild fatigue over several months but denied fever, night sweats, unexplained weight loss, or recurrent infections. There was no history of bleeding or bruising.
On physical examination, he was afebrile and in no acute distress. Small, firm, non-tender cervical lymph nodes were palpable bilaterally. No hepatosplenomegaly was detected. Cardiovascular and respiratory examinations were unremarkable.
Laboratory Findings
|
Test |
Result |
Reference Interval (female) |
Unit |
|
WBC |
17.6 |
4.0-11.0 |
x109/L |
|
RBC |
3.95 |
3.8 – 5.2 |
x109/L |
|
HGB |
12.2 |
11.5 – 15.5 | g/dL |
|
HCT |
36.3 |
34.5 – 45 |
% |
| PLT | 227 | 150 – 400 | x109/L |
Cell Counter Differential:
- Neutrophils: 3.58 × 109/L
- Lymphocytes: 13.16 × 109/L
- Monocytes: 0.76 × 109/L
- Eosinophils: 0.08 × 109/L
- Basophils: 0.04 × 109/L
Analyzer
CellaVision DC-1, WG stain
Sample of cells classified in the Global Test 2025:4

RBC Overview
Case conclusion
Smear Interpretation:
The hematologic profile demonstrates marked absolute lymphocytosis with a predominance of small mature lymphocytes and the presence of smudge cells, consistent with Chronic Lymphocytic Leukemia (CLL). The absence of anemia and thrombocytopenia suggests early-stage (Rai Stage 0) disease.
Diagnosis:
Chronic Lymphocytic Leukemia (CLL), Rai Stage 0
- Evidence: Persistent lymphocytosis, characteristic lymphocyte morphology, and presence of smudge cells.
- Confirmatory test: Flow cytometric immunophenotyping showing monoclonal B cells expressing CD19⁺, CD5⁺, CD23⁺, dim CD20⁺, and weak surface immunoglobulin.
Global Test 2025:4 Results Webinar
Global Test 2025:4
- Case presentation
- DC-1 Analysis- the WBC differential
- Results Overview
- WBC classification, differences between examiner and participants
Discussion about CLL
- From findings to diagnosis
- Role of flow cytometry in CLL diagnosis
- Staging systems and prognostic markers
- Clinical management and follow-up strategies